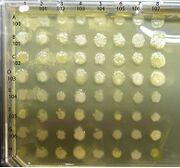
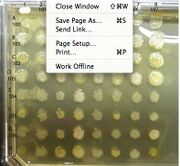
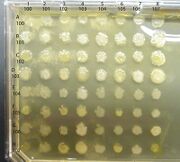

Uploads by Tucker Crum
From OpenWetWare
Jump to navigationJump to search
This special page shows all uploaded files.
| Date | Name | Thumbnail | Size | Description |
|---|---|---|---|---|
| 15:45, 11 November 2013 | Theory Questions Series3 1.docx (file) | 81 KB | ||
| 12:06, 18 October 2013 | Theory Questions Series3.docx (file) | 81 KB | ||
| 16:29, 15 October 2013 | Instructions for DNA sequence analysis F13 1.doc (file) | 46 KB | ||
| 13:54, 24 September 2013 | Series 2 - Linkage Analysis Template v3.pdf (file) | 512 KB | ||
| 18:02, 23 September 2013 | Schema 13F.docx (file) | 95 KB | ||
| 18:01, 23 September 2013 | Schema13fF13.jpg (file) |  |
290 KB | |
| 12:08, 18 September 2013 | Schema13E2.jpg (file) |  |
247 KB | |
| 12:01, 18 September 2013 | Schema 13e2.jpg (file) |  |
204 KB | |
| 12:00, 18 September 2013 | Schema 13e.docx (file) | 96 KB | ||
| 11:59, 18 September 2013 | Schema 13e.jpg (file) |  |
183 KB | |
| 12:33, 4 September 2013 | Schema 13dsm.jpg (file) |  |
73 KB | |
| 12:31, 4 September 2013 | Schema 13d.docx (file) | 99 KB | ||
| 12:31, 4 September 2013 | Schema 13d.jpg (file) |  |
120 KB | |
| 13:06, 23 August 2013 | Switch190sm.jpg (file) |  |
43 KB | |
| 14:01, 21 August 2013 | Illumina sequencing.pdf (file) | 574 KB | ||
| 13:42, 21 August 2013 | DOE JGI Illumina HiSeq handout.pdf (file) | 2.58 MB | ||
| 13:42, 21 August 2013 | Illumina3.jpg (file) |  |
152 KB | |
| 13:41, 21 August 2013 | Illumina2.jpg (file) |  |
142 KB | |
| 13:40, 21 August 2013 | Illumina1.jpg (file) |  |
119 KB | |
| 11:27, 21 August 2013 | Schema 13c.docx (file) | 96 KB | ||
| 11:27, 21 August 2013 | Schema 13c.jpg (file) |  |
87 KB | |
| 00:18, 21 August 2013 | Schema 13b.docx (file) | 95 KB | ||
| 00:17, 21 August 2013 | Schema 13b.jpg (file) |  |
92 KB | |
| 18:21, 27 July 2013 | Schema new 4sm.jpg (file) |  |
38 KB | |
| 18:11, 27 July 2013 | Schema new 4.jpg (file) |  |
107 KB | |
| 18:00, 27 July 2013 | Schema new 4.pdf (file) | 85 KB | ||
| 19:50, 22 July 2013 | 384 well template sm.jpg (file) |  |
63 KB | |
| 13:32, 21 July 2013 | Safety rules micro 3.doc (file) | 138 KB | ||
| 16:02, 3 December 2012 | NEB323-S1.jpg (file) |  |
109 KB | |
| 16:33, 26 October 2012 | BISC219 MM Dos and Don'ts F12.doc (file) | 38 KB | ||
| 15:34, 23 October 2012 | PL4440.jpg (file) |  |
52 KB | |
| 12:14, 18 October 2012 | Instructions for DNA sequence analysis F13.doc (file) | 48 KB | ||
| 14:43, 17 October 2012 | Instructions for DNA sequence analysis F12 4.doc (file) | 49 KB | ||
| 13:07, 17 October 2012 | Instructions for DNA sequence analysis F12 3.doc (file) | 48 KB | ||
| 13:05, 17 October 2012 | Instructions for DNA sequence analysis 3.doc (file) | 48 KB | ||
| 19:40, 16 October 2012 | Instructions for DNA sequence analysis F12 2.doc (file) | 41 KB | ||
| 18:13, 11 October 2012 | Instructions for DNA sequence analysis F12 1.doc (file) | 45 KB | ||
| 13:11, 4 October 2012 | Series 2 Linkage Templates 5.pptx (file) | 73 KB | ||
| 16:24, 3 October 2012 | Genetics 219 Banner 2013 .jpg (file) |  |
228 KB | |
| 14:59, 5 September 2012 | Series 1 Template for CrossesF12.ppt (file) | 187 KB | ||
| 18:47, 10 May 2012 | Hill Rxn M&M.doc (file) | 44 KB | ||
| 18:43, 10 May 2012 | F12-Hill Rxn M&M.doc (file) | 44 KB | ||
| 16:47, 9 May 2012 | How to take gel photos1.doc (file) | 125 KB | ||
| 19:00, 12 March 2012 | Interactions assay 1.jpg (file) | |
59 KB | |
| 18:55, 12 March 2012 | Interaction 4.jpg (file) | |
67 KB | |
| 12:59, 2 March 2012 | BISC209 exosapit 2.jpg (file) |  |
86 KB | |
| 12:39, 18 January 2012 | Interactions assay.jpg (file) | |
139 KB | |
| 14:49, 17 January 2012 | Labnotebookguide 209 4.doc (file) | 52 KB | ||
| 14:23, 17 January 2012 | Safety rules micro 2.doc (file) | 144 KB | ||
| 14:17, 17 January 2012 | Wellesley College Lab Safety 1.doc (file) | 32 KB |